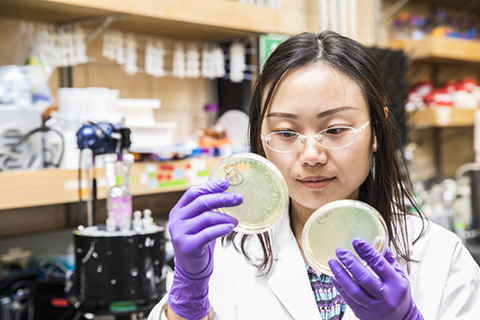

2026 Evans Lecture
Join us April 23 as Deb Niemeier explores what it will take to bring AI from the lab into real-world civil engineering practice.
Event information
The Bridge: Autumn 2025 edition
See what's new with CEE, featuring river temperature research, record enrollment, EV adoption, and more.
Read newsletter
Guidance & leadership
External advisory board
CEE’s External Advisory Board brings real-world perspectives to strategic decision-making, advising on curriculum, research priorities and student career pathways.

Partners in progress
Engage with CEE
Our alumni and industry partners help drive innovation, support students, and shape the future of engineering through mentorship, research and collaboration.

Real-world experience
Student internships
Internships are great practical experience to go along with academics, and create industry connections that can lead to full-time employment.
Department news
-
Apr24Fri
Info Session: Online MS in Civil Engineering - Energy Infrastructure
12:30 pm - 1:30 pm
-
Apr27Mon
CEE Ugrad Drop-In Advising
2:00 pm - 3:00 pm
-
Apr27Mon
A&A Distinguished Speaker Seminar with UC Irvine Professor and Chair Julian Rimoli
4:00 pm - 5:00 pm
Student Union Building (HUB) - 334
-
Apr28Tue
CEE Ugrad Drop-In Advising
11:00 am - 12:00 pm
Alumni stories
Sliding into the Olympic spotlight
CEE graduate Luc Violette balances engineering and elite competition on curling’s biggest stage.

Department spotlight
Michael Dodd
Professor
Michael Dodd studies how light and chemistry can make water safer. His lab designs practical treatment methods that remove pollutants and germs and reduce the risk of drug-resistant infections in communities and health care settings.
RELATED STORY
Studying disinfectants and bacterial DNA
Michael Dodd and his team test common disinfectants to see how well they kill antibiotic-resistant bacteria and break down bacterial DNA linked to resistance.